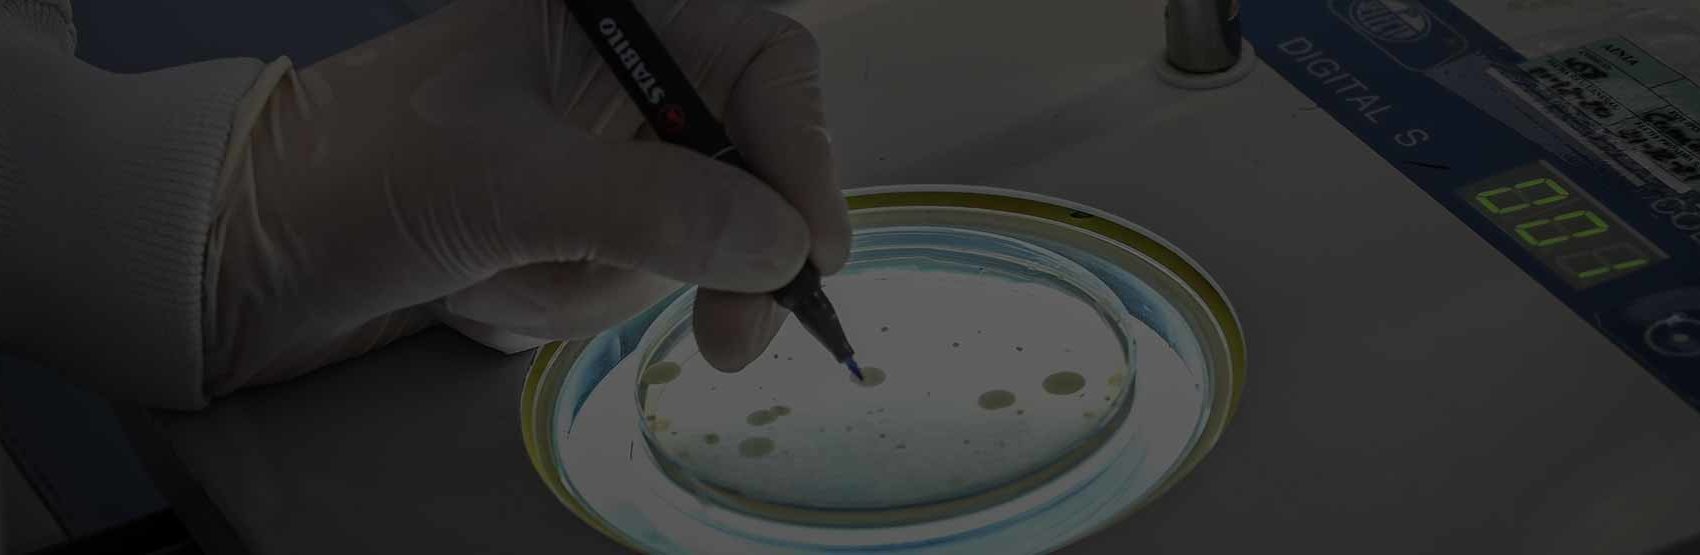

Suscríbete a nuestra newsletter

El control de calidad microbiológico es imprescindible para asegurar la inocuidad y vida útil de los alimentos. La mayoría de las técnicas de detección y recuento de microorganismos es manual. Pese a que en el mercado existen sistemas que realizan esta actividad, son poco precisos. Por este motivo, en AINIA estamos llevando a cabo un proyecto de investigación con el objetivo de crear una herramienta tecnológica que facilite la detección de microorganismos complejos y automatice la lectura de las placas.
La contaminación microbiológica es la principal causa de los problemas sanitarios derivados de la alimentación, por ello, el Reglamento (UE) Nº2073/2005 establece los criterios microbiológicos aplicables a los productos alimenticios, considerando criterios de seguridad alimentaria y criterios de higiene de procesos, fundamentando estos criterios en el análisis microbiológico.
La mayoría de las técnicas de detección y recuento de microorganismos se realizan mediante la siembra en placas con medios de cultivo, debiendo realizar la lectura manual de las colonias crecidas en estas placas, requiriendo para ello, tiempo de los analistas y pudiendo producirse errores. Pese a que en el mercado existen sistemas que realizan esta actividad, son poco precisos debiendo el analista corregir de forma manual el valor de lectura proporcionado por el sistema, siendo una pérdida de tiempo.
Por este motivo, en AINIA estamos llevando a cabo un proyecto de investigación, aunando el conocimiento técnico y experiencia del laboratorio de microbiología y del equipo técnico de automatización inteligente, con el objetivo de crear una herramienta tecnológica que facilite la detección de microorganismos complejos y automatice la lectura de las placas, suponiendo una disminución en el coste de los análisis, un aumento en el número de muestras a analizar a la vez, y una homogenización y objetivación de los criterios de lectura, reduciendo la posibilidad de error.
Concretamente, estamos trabajando en una solución basada en las más innovadoras tecnologías de visión avanzada multiespectral combinadas con inteligencia artificial. En AINIA se ha apostado por la investigación en estas técnicas innovadoras de inspección, desplegando programas internos de I+D+i que permitan desarrollar una plataforma inteligente de análisis de imágenes multifuente con limitaciones de trabajo en tiempo real con la que resolver problemáticas como las planteada. Se cuenta con el apoyo del Instituto Valenciano de Competitividad Empresarial (IVACE), a través de las convocatorias PROMECE, para potenciar la generación de este conocimiento innovador.
La solución permite detectar las diferentes tipologías de colonias y contabilizarlas en cuestión de segundos. Para ello, hace uso de una cámara de visión de alta resolución en tres longitudes de onda capad de identificar pequeñas diferencias y anomalías particulares que presentan las colonias microbiológicas y de un core de inteligencia artificial que interpreta el contenido de la placa que está analizando. Esta herramienta presenta múltiples aplicaciones en el ámbito de la biología y la microbiología, ya que permitirá automatizar la detección y el conteo de las colonias, reduciendo drásticamente el tiempo y estandarizando el proceso frente a la inspección manual.
Esta herramienta permite al técnico de laboratorio centrarse en otras labores de mayor valor, aportando eficiencia y robustez en la medida. Sus principales ventajas son la automatización del proceso, la rapidez en la obtención de las medidas, el entrenamiento personalizado y adaptados a las necesidades del laboratorio, o la alta precisión en los resultados, suponiendo una solución más idónea que la actual. Línea de investigación desarrollada por AINIA en 2021 en el marco de las ayudas IVACE a los centros tecnológicos de la Comunidad Valenciana para proyectos de I+D.


| Responsable | AINIA |
| Domicilio | Calle Benjamín Franklin, 5 a 11, CP 46980 Paterna (Valencia) |
| Finalidad | Atender, registrar y contactarle para resolver la solicitud que nos realice mediante este formulario de contacto |
| Legitimación | Sus datos serán tratados solo con su consentimiento, al marcar la casilla mostrada en este formulario |
| Destinatarios | Sus datos no serán cedidos a terceros |
| Derechos | Tiene derecho a solicitarnos acceder a sus datos, corregirlos o eliminarlos, también puede solicitarnos limitar su tratamiento, oponerse a ello y a la portabilidad de sus datos, dirigiéndose a nuestra dirección postal o a privacy@ainia.es |
| Más info | Dispone de más información en nuestra Política de Privacidad |
| DPD | Si tiene dudas sobre como trataremos sus datos o quiere trasladar alguna sugerencia o queja, contacte al Delegado de protección de datos en info@businessadapter.es o en el Formulario de atención al interesado |
Consiento el uso de mis datos personales para que atiendan mi solicitud, según lo establecido en su Política de Privacidad
Consiento el uso de mis datos para recibir información y comunicaciones comerciales de su entidad.
